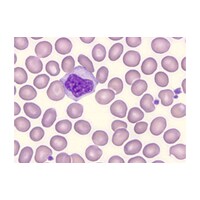

Save up to 60% on our most popular histology products.
Histology laboratories continue to be tasked to do more with less while upholding safe and high-quality results. To better support you, we are delighted to present exclusive promotions on over 950 histology products addressing your needs throughout the entire workflow - from tissue preparation and fixation to processing, embedding, sectioning, staining and imaging.
Use promo code 21687 to access the special prices until April 26, 2024.
Find your products in the categories below.

Embedding
Hematology Stains

Histological and Cytological Stains

Histology Equipment

Histology Reagents

Histology Supplies

Slide Mounting Media

Microscope Accessories

Glass Microscope Slides and Coverslips

